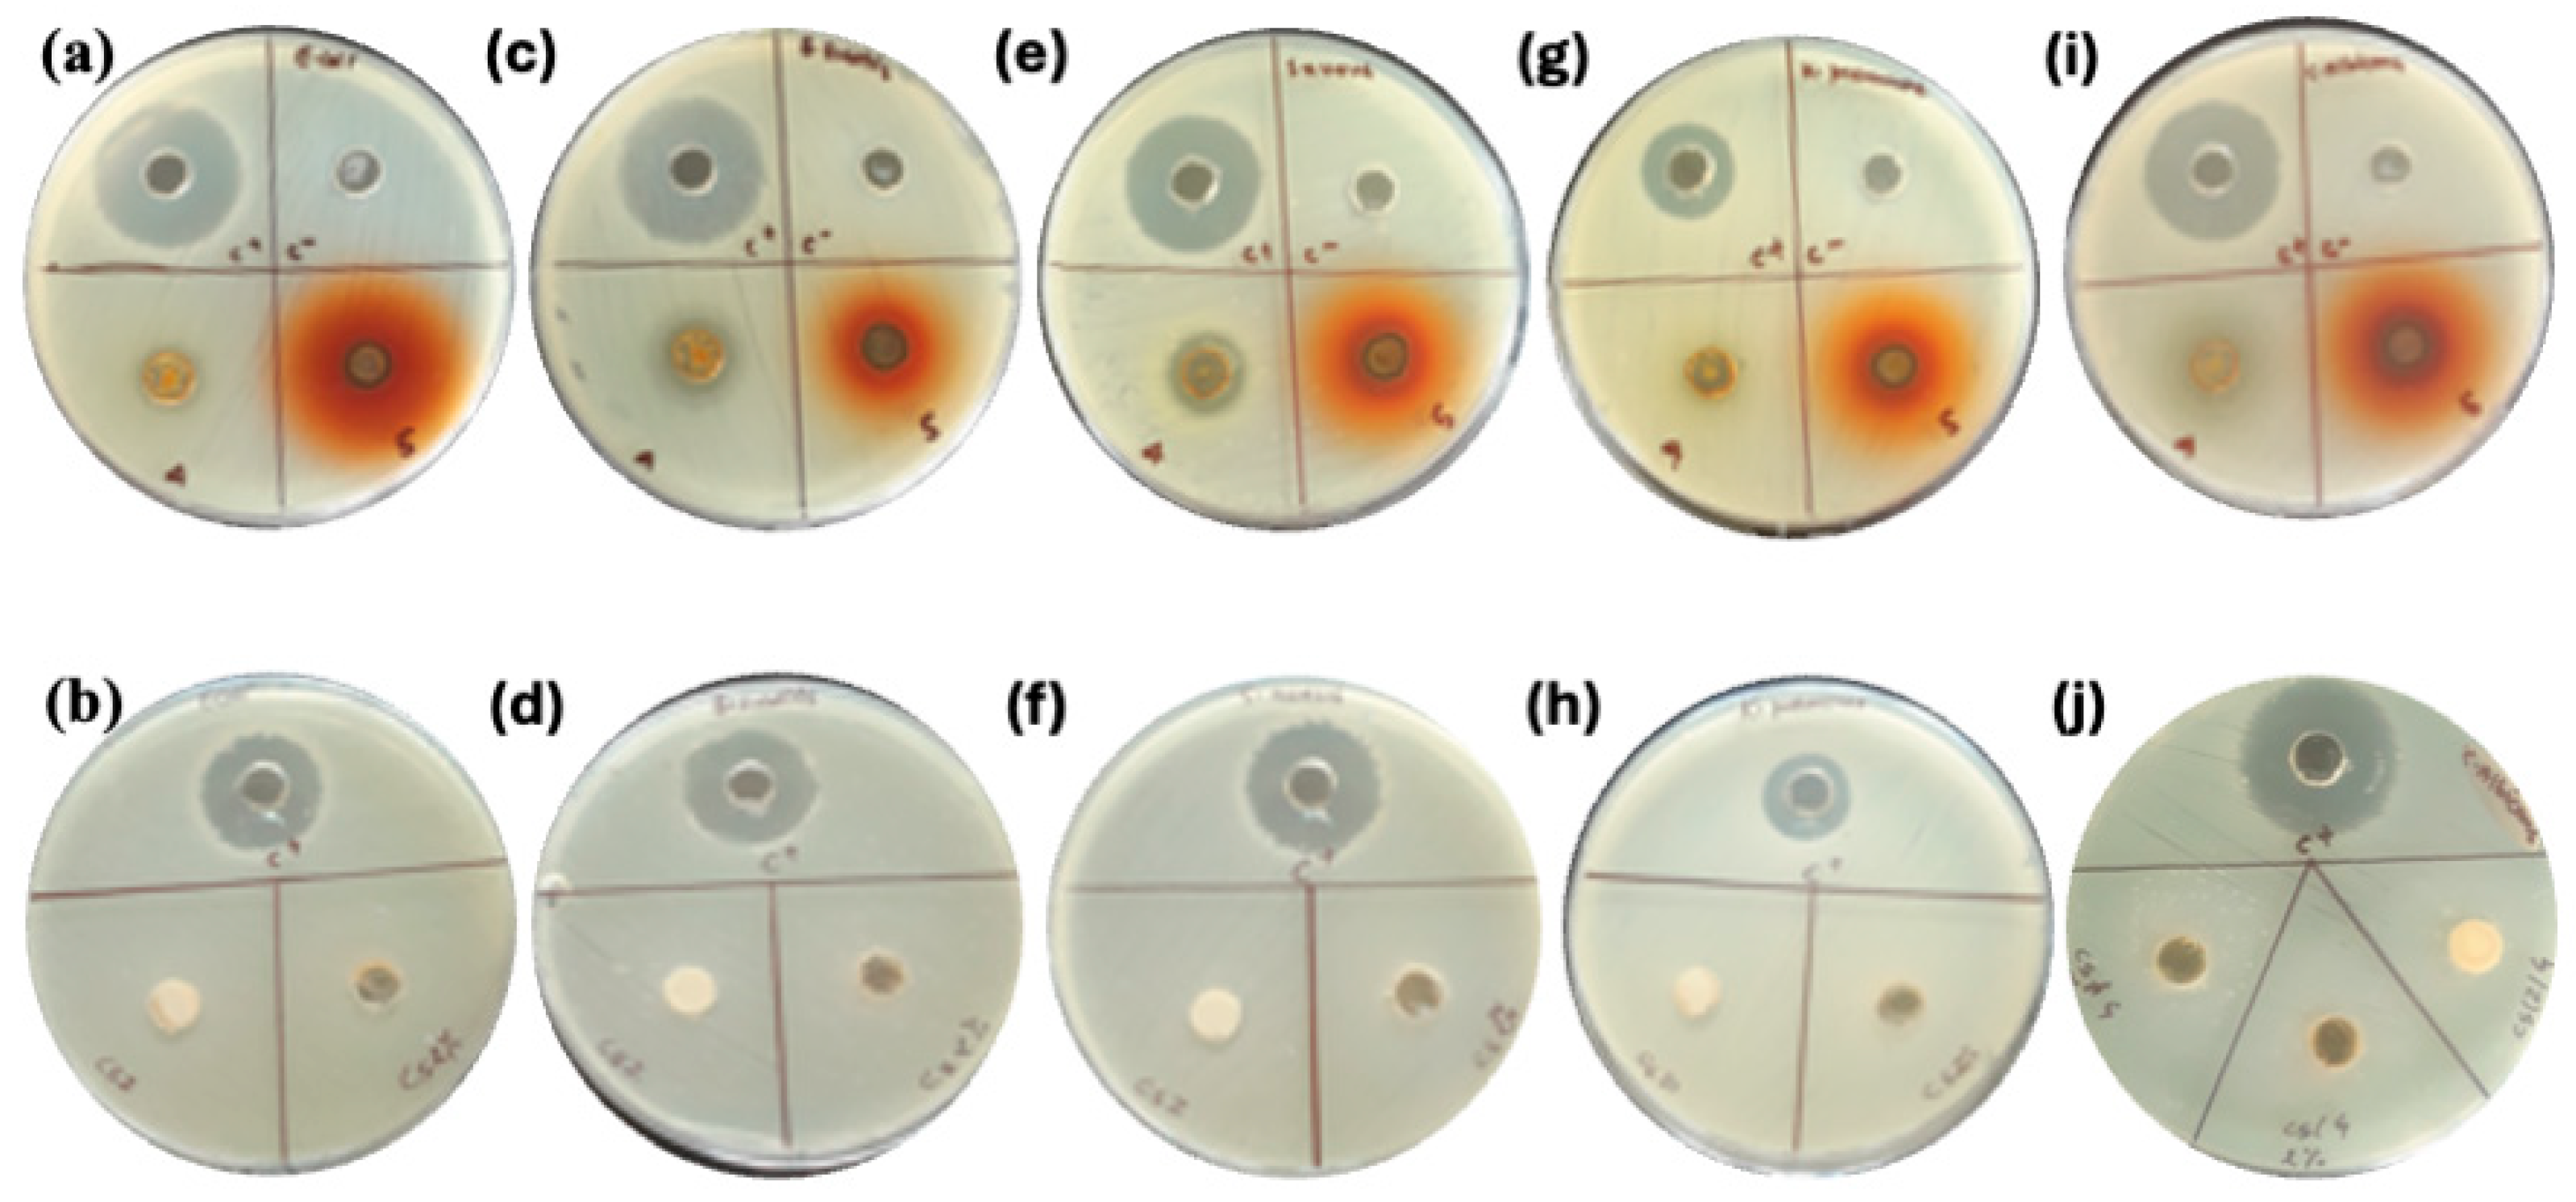
Molecules 30 02311 g004

Chitosan–Zein Films Decorated with Green Synthesized Silver Nanoparticles Using Bergenia ciliata Extract
Abstract
1. Introduction
2. Results and Discussion
3. Materials and Methods
3.1. Materials
3.2. Preparation of BC Plant Extract
3.3. Synthesis of Silver Nanoparticles
3.4. Synthesis of Chitosan–Zein Films Decorated with AgNPS
3.5. Characterization
3.5.1. Morphology and Elemental Mapping
3.5.2. Crystallinity
3.5.3. Thermal Properties and Stability Studies
3.5.4. FTIR Spectroscopic Studies
3.5.5. XPS Spectroscopic Analysis
3.6. Antimicrobial Test
3.6.1. Inoculum Preparation and Plate Inoculation
3.6.2. Disc Accommodation
3.6.3. Incubation
3.7. Biodegradation Test
4. Conclusions
Supplementary Materials
Author Contributions
Funding
Institutional Review Board Statement
Informed Consent Statement
Data Availability Statement
Acknowledgments
Conflicts of Interest
Abbreviations
| AgNPs | Silver nanoparticles |
| CS | Chitosan |
| BC | Bergenia ciliata |
| Z | Zein |
| FESEM | Field emission scanning electron microscopy |
| TGA | Thermogravimetric analysis |
| LB | Liquid broth |
| HRTEM | High-resolution transmission electron microscopy |
| EDX | Energy-Dispersive X-ray Spectroscopy |
| XRD | X-ray Diffraction Spectroscopy |
| FTIR | Fourier transport infrared |
| ATCC | American Type Culture Collection |
| ZOI | Zone of inhibition |
References
- Simon, S.; Sibuyi, N.R.S.; Fadaka, A.O.; Meyer, S.; Josephs, J.; Onani, M.O.; Meyer, M.; Madiehe, A.M. Biomedical Applications of Plant Extract-Synthesized Silver Nanoparticles. Biomedicines 2022, 10, 2792. [Google Scholar] [CrossRef] [PubMed]
- Zhang, X.F.; Liu, Z.G.; Shen, W.; Gurunathan, S. Silver nanoparticles: Synthesis, characterization, properties, applications, and therapeutic approaches. Int. J. Mol. Sci. 2016, 17, 1534. [Google Scholar] [CrossRef] [PubMed]
- Ferdous, Z.; Nemmar, A. Health impact of silver nanoparticles: A review of the biodistribution and toxicity following various routes of exposure. Int. J. Mol. Sci. 2020, 21, 2375. [Google Scholar] [CrossRef] [PubMed]
- Husain, S.; Nandi, A.; Simnani, F.Z.; Saha, U.; Ghosh, A.; Sinha, A.; Sahay, A.; Samal, S.K.; Panda, P.K.; Verma, S.K. Emerging Trends in Advanced Translational Applications of Silver Nanoparticles: A Progressing Dawn of Nanotechnology. J. Funct. Biomater. 2023, 14, 47. [Google Scholar] [CrossRef]
- Stensberg, M.C.; Wei, Q.; McLamore, E.S.; Porterfield, D.M.; Wei, A.; Sepúlveda, M.S. Toxicological studies on silver nanoparticles: Challenges and opportunities in assessment, monitoring and imaging. Nanomedicine 2011, 6, 879–898. [Google Scholar] [CrossRef]
- Bastakoti, B.P.; Guragain, S.; Yusa, S.; Nakashima, K. Novel synthesis route for Ag@SiO2 core-shell nanoparticles via micelle template of double hydrophilic block copolymer. RSC Adv. 2022, 2, 14. [Google Scholar] [CrossRef]
- Bastakoti, B.P.; Torad, N.L.; Yamauchi, Y. Polymeric micelle assembly for the direct synthesis of platinum-decorated mesoporous TiO2 toward highly selective sensing of acetaldehyde. ACS Appl. Mater. Interfaces 2014, 6, 2. [Google Scholar] [CrossRef]
- Banerjee, P.; Satapathy, M.; Mukhopahayay, A.; Das, P. Leaf extract mediated green synthesis of silver nanoparticles from widely available Indian plants: Synthesis, characterization, antimicrobial property and toxicity analysis. Bioresour. Bioprocess. 2014, 1, 3. [Google Scholar] [CrossRef]
- Ansari, M.; Ahmed, S.; Abbasi, A.; Khan, M.T.; Subhan, M.; Bukhari, N.A.; Hatamleh, A.A.; Abdelsalam, N.R. Plant mediated fabrication of silver nanoparticles, process optimization, and impact on tomato plant. Sci. Rep. 2023, 13, 18048. [Google Scholar] [CrossRef]
- Ghasemi, M.; Govahi, M.; Litkohi, H.R. Green synthesis of silver nanoparticles (AgNPs) and chitosan-coated silver nanoparticles (CS-AgNPs) using Ferula gummosa Boiss. gum extract: A green nano drug for potential applications in medicine. Int. J. Biol. Macromol. 2025, 291, 138619. [Google Scholar] [CrossRef]
- Liu, L.; Yu, C.; Ahmad, S.; Ri, C.; Tang, J. Preferential role of distinct phytochemicals in biosynthesis and antibacterial activity of silver nanoparticles. J. Environ. Manag. 2023, 344, 118546. [Google Scholar] [CrossRef] [PubMed]
- Corradini, E.; Curti, P.S.; Meniqueti, A.B.; Martins, A.F.; Rubira, A.F.; Muniz, E.C. Recent advances in food-packing, pharmaceutical and biomedical applications of zein and zein-based materials. Int. J. Mol. Sci. 2014, 15, 22438–22470. [Google Scholar] [CrossRef]
- Lawton, J.W. Plasticizers for Zein: Their Effect on Tensile Properties and Water Absorption of Zein Films. Cereal Chem. 2004, 81, 1–5. [Google Scholar] [CrossRef]
- Pavlátková, L.; Sedlaříková, J.; Pleva, P.; Peer, P.; Uysal-Unalan, I.; Janalíková, M. Bioactive zein/chitosan systems loaded with essential oils for food-packaging applications. J. Sci. Food Agric. 2023, 103, 1097–1104. [Google Scholar] [CrossRef]
- Movaffagh, J.; Nourollahian, T.; Khalatbari, S. Fabrication of Zein-Chitosan-Zein Sandwich-Like Nanofibers Containing Teicoplanin as a Local Antibacterial Drug Delivery System. J. Pharm. Innov. 2023, 18, 911–922. [Google Scholar] [CrossRef]
- Cheng, S.Y.; Wang, B.J.; Weng, Y.M. Antioxidant and antimicrobial edible zein/chitosan composite films fabricated by incorporation of phenolic compounds and dicarboxylic acids. LWT 2015, 63, 115–121. [Google Scholar] [CrossRef]
- Avila, L.B.; Pinto, D.; Silva, L.F.O.; de Farias, B.S.; Moraes, C.C.; Da Rosa, G.S.; Dotto, G.L. Antimicrobial Bilayer Film Based on Chitosan/Electrospun Zein Fiber Loaded with Jaboticaba Peel Extract for Food Packaging Applications. Polymers 2022, 14, 5457. [Google Scholar] [CrossRef]
- Medina-Jaramillo, C.; Ochoa-Yepes, O.; Bernal, C.; Famá, L. Active and smart biodegradable packaging based on starch and natural extracts. Carbohydr. Polym. 2017, 176, 187–194. [Google Scholar] [CrossRef]
- Gurung, S.; Sarmin, M.; Hoda, M. Implications of White Light-Emitting Diode-Based Photoirradiation on Green Synthesis of Silver Nanoparticles by Methanol- and Aqueous-Based Extracts of BC Leaves. Nanomaterials 2024, 14, 1327. [Google Scholar] [CrossRef]
- Sherpa, L.; Nimmala, A.; Rao, S.V.S.N.; Khan, S.A.; Pathak, A.P.; Tripathi, A.; Tiwari, A. Refining shape and size of silver nanoparticles using ion irradiation for enhanced and homogeneous SERS activity. Discov. Nano 2024, 19, 51. [Google Scholar] [CrossRef]
- Zhang, L.; Liu, Z.; Wang, X.; Dong, S.; Sun, Y.; Zhao, Z. The properties of chitosan/zein blend film and effect of film on quality of mushroom (Agaricus bisporus). Postharvest Biol. Technol. 2019, 155, 47–56. [Google Scholar] [CrossRef]
- Reis, R.S.; Tienne, L.G.; de Souza, H.S.D.; Marques, M.D.; Monteiro, S.N. Characterization of coffee parchment and innovative steam explosion treatment to obtain microfibrillated cellulose as potential composite reinforcement. J. Mater. Res. Technol. 2019, 155, 47–56. [Google Scholar] [CrossRef]
- De Almeida, C.B.; Corradini, E.; Forato, L.A.; Fujihara, R.; Fiiliho, J.F.L. Microstructure and thermal and functional properties of biodegradable films produced using zein,” Jahrb. für Philos. Kult. Gesellschaft 2020, 9, 9412–9421. [Google Scholar]
- Davies, M.; Evans, J.C.; Jones, R.L. Molecular interaction and infra-red absorption spectra: Part 4—Methyl acetamide. Trans. Faraday Soc. 1955, 51, 761–774. [Google Scholar] [CrossRef]
- Sałdyka, M.; Mielke, Z.; Haupa, K. Structural and spectroscopic characterization of DMF complexes with nitrogen, carbon dioxide, ammonia and water. Infrared matrix isolation and theoretical studies. Spectrochim. Acta Part A Mol. Biomol. Spectrosc. 2018, 190, 423–432. [Google Scholar] [CrossRef] [PubMed]
- Garavand, F.; Khodaei, D.; Mahmud, N.; Islam, J.; Khan, I.; Jafarzadeh, S.; Tahergorabi, R.; Cacciotti, I. Recent progress in using zein nanoparticles-loaded nanocomposites for food packaging applications. Crit. Rev. Food Sci. Nutr. 2024, 64, 3639–3659. [Google Scholar] [CrossRef]
- Hayashida, K.; Tsuda, Y.; Yamada, T.; Yoshigoe, A.; Okada, M. Revisit of XPS Studies of Supersonic O2 Molecular Adsorption on Cu(111): Copper Oxides. ACS Omega 2021, 6, 26814–26820. [Google Scholar] [CrossRef]
- Santerre, F.; El Khakani, M.A.; Chaker, M.; Dodelet, J.P. Properties of TiC thin films grown by pulsed laser deposition. Appl. Surf. Sci. 1999, 148, 24–33. [Google Scholar] [CrossRef]
- Azarian, M.H.; Nijpanich, S.; Chanlek, N.; Sutapun, W. Probing capping mechanisms and polymer matrix loading of biogenic vaterite CaCO3-Ag hybrid through X-ray photoelectron spectroscopy (XPS). RSC Adv. 2024, 14, 14624–14639. [Google Scholar] [CrossRef]
- Yin, I.X.; Zhang, J.; Zhao, I.S.; Mei, M.L.; Li, Q.; Chu, C.H. The antibacterial mechanism of silver nanoparticles and its application in dentistry. Int. J. Nanomed. 2020, 15, 2555–2562. [Google Scholar] [CrossRef]
- Dakal, T.C.; Kumar, A.; Majumdar, R.S.; Yadav, V. Mechanistic basis of antimicrobial actions of silver nanoparticles. Front. Microbiol. 2016, 7, 1831. [Google Scholar] [CrossRef] [PubMed]

| Strain | Reference Culture | Type | C+ Kanamycin | * Effectiveness (Inhibition Zone, mm) | ||
|---|---|---|---|---|---|---|
| CS-Z Control | CS-Z-BC 400 | CS-Z-BC-AgNPs | ||||
| Escherichia coli | ATCC8739 | Gram −ve | 26 | ND | 12 | 18 |
| Klebseilla pneumoniae | ATCC 700603 | Gram −ve | 18 | ND | 14 | 15 |
| Bacillus subtilis | ATCC 6051 | Gram +ve | 25 | ND | 14 | 17 |
| Staphylococcus aureus | ATCC6538P | Gram +ve | 25 | ND | 13 | 16 |
| Candida albicans | ATCC2091 | Fungi | 27 | ND | 22 | 17 |
| Day/Sample | CS | CS-Z | CS-Z-BC400 | CS-Z-BC400-AgNPs |
|---|---|---|---|---|
| 1 | 0.111 | 0.096 | 0.127 | 0.140 |
| 7 | 0.094 | 0.078 | 0.125 | 0.137 |
| 14 | 0.0631 | 0.074 | 0.087 | 0.1023 |
| 21 | 0.057 | 0.047 | 0.072 | 0.084 |
| 28 | 0.053 | 0.043 | 0.071 | 0.083 |
| Wt. Loss % | 52.45% | 55.21% | 44.09% | 40.71% |
Disclaimer/Publisher’s Note: The statements, opinions and data contained in all publications are solely those of the individual author(s) and contributor(s) and not of MDPI and/or the editor(s). MDPI and/or the editor(s) disclaim responsibility for any injury to people or property resulting from any ideas, methods, instructions or products referred to in the content. |
© 2025 by the authors. Licensee MDPI, Basel, Switzerland. This article is an open access article distributed under the terms and conditions of the Creative Commons Attribution (CC BY) license (https://creativecommons.org/licenses/by/4.0/).
Share and Cite
Chand, A.B.; Ashie, M.; Dahal, R.; Joshi, R.D.; Tiwari, A.P.; Joshi, M.K.; Bastakoti, B.P.; Kalauni, S.K. Chitosan–Zein Films Decorated with Green Synthesized Silver Nanoparticles Using Bergenia ciliata Extract. Molecules 2025, 30, 2311. https://doi.org/10.3390/molecules30112311
Chand AB, Ashie M, Dahal R, Joshi RD, Tiwari AP, Joshi MK, Bastakoti BP, Kalauni SK. Chitosan–Zein Films Decorated with Green Synthesized Silver Nanoparticles Using Bergenia ciliata Extract. Molecules. 2025; 30(11):2311. https://doi.org/10.3390/molecules30112311
Chicago/Turabian StyleChand, Ananda Bahadur, Moses Ashie, Rabin Dahal, Ram Datt Joshi, Arjun Prasad Tiwari, Mahesh Kumar Joshi, Bishnu Prasad Bastakoti, and Surya Kant Kalauni. 2025. "Chitosan–Zein Films Decorated with Green Synthesized Silver Nanoparticles Using Bergenia ciliata Extract" Molecules 30, no. 11: 2311. https://doi.org/10.3390/molecules30112311
APA StyleChand, A. B., Ashie, M., Dahal, R., Joshi, R. D., Tiwari, A. P., Joshi, M. K., Bastakoti, B. P., & Kalauni, S. K. (2025). Chitosan–Zein Films Decorated with Green Synthesized Silver Nanoparticles Using Bergenia ciliata Extract. Molecules, 30(11), 2311. https://doi.org/10.3390/molecules30112311

